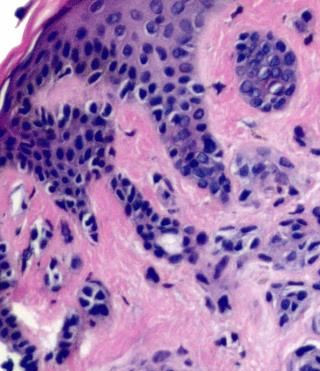

黑色素瘤,通常是指惡性黑色素瘤,是黑色素細胞來源的一種高度惡性的腫瘤,簡稱惡黑,多發生于皮膚,也可見于黏膜和内髒,約占全部腫瘤的3%。皮膚惡性黑色素瘤占皮膚惡性腫瘤的第三位(約占6.8%~20%)。好發于成人,皮膚白皙的白種人發病率高,而深色皮膚的亞洲人和非洲人發病率較低,極少見于兒童。部分患者有家族性多發現象。 惡性黑色素瘤可由先天性或獲得性良性黑素細胞痣演變而成,或由發育不良性痣惡變而來,也可以是新發生。近年來,惡性黑色素瘤的發生率和死亡率逐年升高,與其他實體瘤相比,其緻死年齡更低。惡性黑色素瘤除早期手術切除外,缺乏特效治療,預後差。因此,惡性黑色素瘤的早期診斷和治療極其重要。









